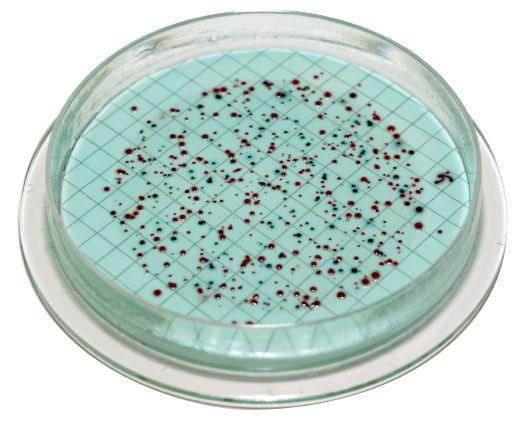

www.groundwatercanada.com
Grappling with ground water
How associations and drillers can help influence policy and stewardship


EXPANDING YOUR PUMPING CAPABILITIES
VR Series vertical multi-stage pumps are now available in 3, 5, 9, 15, 20, 30, 45, 65, and 95 m3/h options with all 316 stainless steel hydraulics for superior durability, efficiency, and performance. The rugged components ensure long operating life in the toughest applications: water treatment; water supply and pressure boosting; heating, ventilation and air conditioning; light industry; irrigation and agriculture.
Experience Innovation. Experience Franklin.



41, No. 4
Annex Publishing & Printing Inc.
P.O. Box 530, Simcoe, Ontario N3Y 4N5 (800) 265-2827 or (519) 429-3966 Fax: (519) 429-3094
editor | Laura Aiken laiken@annexweb.com (416) 522-1595
associate editor | Colleen Cross ccross@annexweb.com (519) 428-3471
sales manager | Ed Cosman ecosman@annexweb.com (519) 429-5199, (888) 599-2228, ext 276
account coordinator | Barb Comer bcomer@annexweb.com (519) 429-5176, (888) 599-2228, ext 235
media designer | Alison Keba akeba@annexweb.com
Group publisher | Martin McAnulty mmcanulty@annexweb.com
director of soul/coo | Sue Fredericks
Publication Mail Agreement #40065710. RETURN UNDELIVERABLE CANADIAN ADDRESS TO CIRCULATION DEPARTMENT, P.O. BOX 530, SIMCOE, ON N3Y 4N5
e-mail: subscribe@groundwatercanada.com
Printed in Canada, All rights reserved. Editorial material is copyrighted. Permission to reprint may be granted on request. ISSN 0383-7920
Circulation
e-mail: subscribe@groundwatercanada.com Tel: 866-790-6070 ext. 208 Fax: 877-624-1940
Mail: P.O. Box 530, Simcoe, ON N3Y 4N5
Subscription Rates
Canada - 1 Year $42.00
(plus 5% GST - $44.10)
U.S.A. - 1 Year $60.00
Occasionally, Ground Water Canada will mail information on behalf of industry-related groups whose products and services we believe may be of interest to you. If you prefer not to receive this information, please contact our circulation department in any of the four ways listed above.
Serving the Canadian ground water industry for 41 years.

8 GrapplinG with G round water, part 2 We consider ground water management at the federal level and the role of associations and drillers
12 tradition and tech Integrity and forward thinking has sustained Hawkes Well Drilling for nearly seven decades
18 samplinG for bacteria Ken Hugo’s review of methods suggests this procedure is not always straightforward
26 o Gwa conference News and research from the June convention
ON THE WEB:



Cape Breton U study to examine geothermal energy Cape Breton University’s Verschuren Centre is partnering with the Cumberland Energy Authority on a geothermal study relating to the former Springhill mine, the Cape-Breton Post reports.
Fowler recognized by NGWA for contributions to ground water
www.groundwatercanada.com
Former National Ground Water Association president Scott Fowler of Dahlman Pump & Well Drilling Inc., Burlington, Wash., has received NGWA’s top honour as recipient of the Ross L. Oliver Award for outstanding contributions to the ground water industry.
Sharpening the saw
Balancing pressing business with maintenance, and assessing the big picture, can make you more productive

by Colleen Cross
it’s so easy to deal with the fires, isn’t it? And by easy I mean not easy but straightforward. As each pressing issue comes up, you swing into action. As each new job appears, you make hay while the sun shines by eagerly taking it on.
Ontario Ground Water Association president Darren Juneau reminded us how important it is to balance new and pressing business with regular maintenance. In his spring newsletter address, Juneau said the board had worked on items that impact the organization and members and not enough on the organization itself. “All of our energy goes into dealing and negotiating with organizations like Ontario College of Trades, Ministry of Environment and Climate Change, and Electrical Safety Association on items that have a direct impact on our members. Of equal importance is the work being done on our by-laws to be compliant with new regulations...”
The phrase alludes to the example of a person who’s been trying to saw down a tree for five hours and is getting nowhere.
Questions like “How do we deal with complaints?” and “Where are we headed?” often are neglected in favour of more pressing issues, Juneau said, comparing the situation to his own shop’s decision to prioritize maintenance and pass up on jobs so the company’s rigs could get fixed properly in the shop.
We all need to perform those everyday tasks, and in the drilling business that means everything from the mundane (tuning up rigs, reviewing safety procedures, backing up computer files) to the motivating (asking for employee feedback, organizing social events).
Stephen Covey’s self-help book 7 Habits of Highly Effective People identifies a principle he calls “sharpening the saw” that encompasses this important, supportive work.
The phrase alludes to the example of a person who’s been trying to saw down a tree for five hours and is getting nowhere. When asked why he doesn’t stop sawing, sharpen his saw, then go back
to sawing, he says he doesn’t have time to stop and sharpen his saw because he’s too busy sawing.
The author’s formula for physical, social, emotional, mental and spiritual self-renewal and a balanced life is a program for personal growth. But it translates well to the workplace.
The process is intended to keep you fresh so you can increase your capacity – and your business’s capacity – to produce and handle the challenges around you. Without this renewal, the business may become stagnant and weak.
There are two broad ways to sharpen your saw, or drill bit: be consistent in your everyday operations and take time to look at the big picture. This last idea of recharging, which lends itself to the slower season, helps us avoid mental and physical burnout and also pushes us to answer one of Juneau’s questions: “Where are we going?”
This stirs up other, more specific, questions: How much do you want to grow your business and how fast? What kind of business do you want to be? How do you want customers to describe you? How do you want employees to describe you?
Pinning down answers can have unexpected benefits. It can help you attract talented and forward-thinking employees: the good ones. These days the good ones are looking for employers who have a long-term plan, keep up with new technology and see themselves as part of a larger picture of industry sustainability. They value employers who take steps to ensure their employees’ well-being such as prioritizing safety, and helping them hone technical and “soft” skills. These elements raise morale, lead to good word of mouth and bring employees to your doorstep.
However you choose to do it, sharpening your saw and helping others sharpen theirs is good for everyone and good for business.






Galvanized support bar at top of well casing holds more weight-easy connection at top

304 Stainless Steel discharge hub clamps around casing (easy installation)
304 Stainless steel construction best long term material
Simple, positive mechanical seal by turning a stainless steel screw Can not be dropped down inside well

themselves


INDUSTRY NEWS

SkyTEM To MAp AqUIFE r S F or G E oSCIENCE BC’S pEACE proj ECT
Geoscience BC has chosen helicopter-borne geophysical company SkyTEM Canada to fly the 2015 Peace Project Phase I airborne electromagnetic survey over northeast British Columbia’s Peace Region.
The Peace Project will generate new information about groundwater that will facilitate its protection, initially within an 8,000-square-kilometre region that stretches from Hudson’s Hope and Fort St. John northwest to between Pink Mountain and Trutch. The Phase I airborne survey component of the Peace Project was slated to start in mid-July and depending on weather, will take approximately 40 days to complete.
SkyTEM, which has an office in Ayr, Ont., is a helicopter-borne geophysical system designed specifically to map aquifers. The Danish Ministry of Environment developed SkyTEM in the late 1990s to collect the data necessary for making critical decisions about the protection and sustainability of Denmark’s ground water resources.
Bailey Helicopters Ltd., headquartered in Fort St. John, has been retained to fly the SkyTEM system for the Peace Project airborne survey.
The Peace Project was announced in March 2015 and is a collaborative effort that will help to increase understanding of surface and ground water resources in the Peace Region. Project partners include the BC Oil and Gas Commission, the BC Oil and Gas Research and Innovation Society, Conoco Phillips Canada, Progress Energy Canada Ltd., the Province of British Columbia, and the Northern Development Initiative Trust (NDIT).
Gr UNDF oS WALk F or WATE r
SET F or S E pTEMBE r
Grundfos Canada’s 3rd Walk for Water event will help bring clean drinking water to communities in need.
The Grundfos Walk for Water is a fundraising event developed in partnership with Water Missions International. The initiative aims to raise money for impoverished communities in South and Central America and Africa to build wells that will provide residents with clean, sustainable drinking water.
This year’s event will be held Sept. 19, from 1 to 3 p.m. at Lion’s Valley Park in Oakville, Ont.
“We walk the 5 km trail with a water bucket, fill it with water at the halfway point and carry it to the finish to experience what many must do each day to survive,” Simon Fedeema, president of Grundfos, wrote in an email announcing the event. “We know we cannot quickly solve the global water crisis, but with your help, we can save lives and give communities in need clean, sustainable drinking water.”
This year’s event has a fundraising goal of $20,000.

“Water Missions International has been working with Grundfos in many projects over the past five years and is using our pump technology to provide life-sustaining clean water to those who need it the most,” Feddema added. “Grundfos Canada continues to work alongside them and other Grundfos companies in North America to spread awareness about the global water crisis and provide an opportunity so that we can help in providing more wells and clean water for those in need.”
Screening tool helpS protect StreamS, wetlandS, homeS from landfill riSkS
A new screening tool to assess the potential risk posed by contaminated ground water moving from landfills to nearby streams, wetlands and residences has been developed by the U.S. Geological Survey and the New Jersey Pinelands Commission.
The recently published article in Waste Management Journal presents the innovative method to assign “levels of concern” to landfills based on a new modeling method, the USGS said in a news release.
The tool uses monitoring well and hydrologic data, physical characteristics of the landfill (or other point source) and chemical properties of the contaminant(s) to estimate ground water contaminant concentrations at receptor locations.
“The method is suitable for a screening-level assessment of the risk posed by a landfill or other contaminant point source, and can be used by regulators and managers using basic spreadsheets,” said Ron Baker, a hydrologist with the U.S. Geological Survey and lead author of the study.



Grapplin G with G round water
this second instalment looks at the role drillers and associations can play in ground water management
what role can and does the c anadian ground water industry play in protecting a resource that has become a hot topic worldwide?
by Carolyn CaM illeri
While steps are being made, some feel strongly that Canada needs to move a lot faster at the federal level.
“My concern is that Canada is really not very prepared for demands on water, especially on ground water,” says K.C. Craig Stainton, executive director of the Ontario Ground Water Association (OGWA). “I am cognizant of federal participation in discussions such as the Great Lakes agreement but certainly not around ground water. So I don’t think Canada is at all prepared: it has no realistic handle on the value of ground water or of the well.”
Getting more federal attention for ground water brings up a concept that has been bandied about for years.
“The problem comes down to there is really no national ground water policy. It is dropped onto the provinces and each provincial environment ministry polices their own,” says Kevin Constable, owner of Fred Constable and Sons drilling and former president and board member with the OGWA.
Rivera says a national ground water policy could be beneficial when it comes to transboundary aquifers, but he is hesitant about aquifers within provinces.
“Part of the reason it is challenging here is that we are a federation,” Rivera says. “You cannot separate policy and jurisdiction and government from what we do. I am sure by gathering the right people together, they could prepare a national policy; however, as soon as you tried to implement it, there would be a lot of resistance.”

It wouldn’t be the first time a national policy was considered. In 1987, a federal water policy was created.
“It is still a reference, but it was never implemented, it was never voted in and there were very good things and points in it,” Rivera says. “And that was water resources all together.”
For Stainton, it is less about the lack of a policy than it is about the lack of coordination and enforcement.
“If there was someone who could look at every aspect of the ground water industry and its relationships with all the ministries and co-ordinate everything into a cohesive, sensible approach that could be enforced in a straightforward manner, our ground water would be safe. We would know what we have and be on a perfect and level playing field when someone like the U.S. said they wanted some, or for that matter, when a large corporation tried to make it an export commodity.”
With that, Stainton reveals a worry that is particularly sensitive publicly: selling water.
“There needs to be discussion around uniform protection for ground water aquifers across Canada and certainly preliminary discussions around the value of ground water,” he says. “Who does it belong to? Does it belong to the highest bidder, the people of Canada, the government of Canada, the person who owns the property the well that produces it is on?”
These are considerations that may need to be taken into account in a time of rationing, Stainton adds. His concern is that if Canada were faced with a large demand for water, the reaction would be influenced by factors outside the best interests of ground water.
“I would bet when it finally came down to ground water and know-how, ‘well drillers’ would be the last to be consulted,” he says.
And yet, consulting with drillers may be exactly what is needed.
“That’s an important connection, where the drilling industry has on-theground, practical experience that is really useful when developing regulations, and then vice versa, when you are developing regulations, there needs to be a lot of outreach and there needs to be a lot of education and communication with the industry,” Gleeson says.
Rivera also comments on the critical role drillers and associations play.
“At the end of the day, the wells are the eyes of the aquifers: the only way that you can ‘see’ aquifers is with wells,” he says. “So associations and drillers are a big important part of it – the collection of data that they come up with from

the wells, the tests that they do to get the yield of the well, the way they report that, the standard that they use, the way that they inform the public – in the end, it is their data that we are going to use to access and make sense of the aquifers.”
Maybe it’s time for the industry to speak a little louder.
G IVING INDUSTRY A VOICE
It has been noted that industry participation in federal ground water discussions may be more likely if there were a national representative – which naturally points to the rebirth of the Canadian Ground Water Association (CGWA).
“We in B.C. would see a new Canadian association as the link to the federal government,” former BCGWA managing director Bruce Ingimundson says. “They could be the group that would lobby the federal government for whatever is needed, whether it be more mapping or finances or some form of regulation.”
He adds that a provincial association going alone to the federal government wouldn’t carry much weight, but that a representative for the whole country would have a greater chance of getting results.
Stainton agrees, adding the CGWA, when it existed previously, provided a unified voice from a national perspective.
“I had always hoped the time would come where the CGWA would begin to
advocate on ground water issues with the federal government,” he says. “I believe that to be one of the only ways to lobby for ground water to the federal government and it needs to be happening.”
A national association would also form a cohesive link between the provinces.
“My thoughts on a new Canadian association would be to put the provinces’ representatives in the same room and share ideas on problems that exist across the country – find solutions,“ Constable says. “If the associations have any kind of strength in their own individual provinces, the Canadian ideas can go back to these provinces with probably a little bit more clout.”
Rivera was involved with the CGWA when Maurice Lewis (who has since passed away) was executive director. The CGWA participated in the preparation of the report “Canadian Framework for Collaboration on Groundwater” in 2003. Establishing nationally consistent education and certification for hydrogeologists and drillers was one recommendation of that report.
Constable is on side with that idea.
“The biggest advantage of having a Canadian association would be for training, certification, education – call it a clearing house for lack of a better word – where the Canadian association would be more in tune with whatever people across the country needed,” he says,
Gilles Leclaire
Lalande

adding that the training programs and certification exams could be shared with provinces that didn’t have them.
Another example of how CGWA would be beneficial to the overall management of ground water is in establishing national standards for the collection of data.
“We require national standards that we do not currently have,” Rivera says. “As scientists, before you invest money drilling wells, for instance, we collect data that already exists. And most of the time, we are faced with the values or reports from the drillers that are difficult to interpret for several reasons. One of them is that it is not standard because there is no national vision on that.”
Well yields and water meters to measure ground water usage is another area that standards instituted through a national association would be able to provide.
A national association could also institute standards for well yields and water meters to measure usage.
“Those types of things are very valuable – and those could come or should come from industry, and the CGWA was well suited to do that,” Rivera says.
“I would strongly encourage that [the CGWA] comes back because we need that in Canada. It’s not just science. We also need technology: science and technology working together,” he says.
‘At the end of the day, the wells are the eyes of the aquifers: the only way that you can “see” aquifers is with wells.’ –Alfonso Rivera
“B.C. hosted Canwell 2014 last year, and we actually had a session on a Canadian association and there seemed to be a reasonable amount of support,” Ingimundson says, adding that the National Ground Water Association in the U.S. has offered to assist with setting it up.
“Of course, they’re much larger, so it’s hard to compare in some ways, but they have a very broad range of activities, not focused on one thing, such as certifying, and that’s what we need to adopt.”
The problem comes with getting started.
“There was no followup. Nobody wanted to talk to anybody else, for whatever reason,” Ingimundson says.
“It is past being my job to look after it,” Constable says. “But some of the executive directors from the provincial associations need to talk, and somebody needs to organize a meeting someplace and sit down and hammer it out amongst representatives from each provincial association.”
“Somebody has to take the bull by the horns and make this happen.”
Carolyn Camilleri has been a writer and editor in Victoria for the past 15 years and now divides her time between Toronto and Vancouver island, writing for several trade and consumer magazines across the country.










tradition and tech
integrity and forward thinking has sustained family business hawkes well drilling for nearly seven decades
working in the family’s well drilling business was something d arrell c arson always talked about, but his career path made a few twists and turns before that became a reality.
by Julie FiTz-Gerald
The late Anthony Hawkes, Carson’s grandfather, founded Hawkes Well Drilling & Pump Service in 1947. The company, located in Lower Coverdale, N.B. – about 10 minutes from Moncton – was a true family affair with several family members working in or owning the business over the years.
Carson, however, studied electronics in college and began working for a gaming company in Montreal soon after. It was a job he enjoyed, but New Brunswick always seemed to be beckoning him home. Eventually, Carson decided to swap an office chair for a drill rig.
He began working alongside his father, Cyrus Carson, on the job site, learning the ropes before buying the business from him in 2011. Now as a third-generation owner of Hawkes Well Drilling, Carson is carrying on the family business,
keeping it true to its roots while incorporating advancements in technology.
Working in the fresh east coast air has been a welcomed change from the office environment of his previous job. “I enjoy getting out and working with my hands. You get to see so many aspects, from the business side of things to the labour part of it. I enjoy going out and meeting people. Whether drilling wells or doing service work, you get to go out and talk to the customers,” he says.
Carson prides himself on the company’s longstanding reputation for honesty and hard work and always knew it was a tradition to take very seriously. “Doing the job and doing it properly: that’s where I know a lot of businesses with succession tend to fail because sometimes the younger generation isn’t willing



overburden formations, including sand, gravel, glacial till, and boulders.
2. Open-Hole Versatility - The DR can be configured for a variety of drilling methods including mud, reverse circulation, and flooded reverse circulation.
3. Straight Holes - The rotation of the casing by the lower drive results in a very straight hole making it ideal for shaft holes and foundation piles. This also minimizes stress on casing and casing welds, and eases the task of installing screens and pumps in water well applications.
4. Basin Extraction - The lower drive is equally effective at pulling back casing; thereby simplifying the process of exposing a well screen or abandoning a well.
5. Utilizes Conventional Tools - The drill string can be equipped with down-the-hole hammer, roller cone, or drag bit.
6. Control of Discharge - Cuttings are diverted through the discharge swivel and can be directed to a safe and convenient dumping or monitoring point.

7. Ease of Maintenance - Foremost DR rigs feature a directly connected hydraulic feed system which means no chains, sheaves, or sprockets to maintain. This type of feed system generates zero load on the mast crown, permitting a simple and lightweight mast design that does not sacrifice pullback capability.
8. Reduced Operational Risk - The DR’s flexibility allows you to expand into new applications and gives you confidence to go into areas previously considered off-limits. You will know you have the right equipment to get the hole down the first time!
9. Resale Value - There is arguably no drill on the market today that holds its value better than a Foremost DR. Dual Rotary owners tend to hold onto their rigs, making used inventory scarce, making for easy re-sale should the need arise.
10.Foremost Technical Support – Foremost’s DR rigs are backed by the expertise and support of our product management team, field technicians, and one of the largest engineering departments in the industry.



to put in the effort. You have to keep things operating the way they always have been while moving forward. Keeping up with new technology, but keeping the work ethic that the company’s been known for,” he explains.
Hawkes Well Drilling primarily services the Moncton area, travelling a 90-minute radius from the city centre. The business is a small operation run entirely by the family deploying one 22W drill rig and two service trucks. Amanda Carson, Darrell’s wife and co-owner of the company, keeps the office running smoothly, dealing with paperwork and back-end operations. Darrell and Cyrus can be found on the job site, drilling and repairing wells, servicing and installing pumps, and providing water treatment.
Much of their 22W cable-tool rig has been converted to hydraulics, including the elevator, levelling jacks, hydraulic breakout and derrick hoist. “We’ve stayed with the cable-tool operation. It seems the [drilling] market is shrinking; there’s not as much work there as there used to be. There is a lot more service and repairs for wells, so we didn’t want to get into bigger equipment that requires more work.”
With the service side of the business expanding, the company has added water quality testing equipment, pump pullers, digital flow metres and Well-Vu cameras to its equipment list in order to better diagnose customers’ water issues.
It’s this kind of customer-oriented attitude that has allowed the company to successfully span nearly seven decades. Darrell says responding to customers’ calls quickly and with a high degree of workmanship has fostered a sense of reliability and trust between him and his clients. “Word-of-mouth is really important. We don’t do a lot of advertising, just some signage, but a lot of our work is word-of-mouth and references. Relationship with the customer is crucial. With rotary you’re in and out, but with cable-tool technology, you get to know the customer. They come out and watch, they learn about the operation, and that helps to build a relationship with them. I enjoy that.”
As a member of the New Brunswick Ground Water Association, Carson says stays current with proposed changes to the industry and play an active role in

how the industry moves forward. “Some changes that come out are for the better, but some in our opinion aren’t really helpful, so we try to help influence those. Whatever regulations do come out, we make appropriate changes to comply with rules and regulations.”
Attending trade shows and pump seminars, particularly in the Maritimes, is another way Carson stays up to date with the industry’s latest technological advancements. “I keep up to speed with the new products coming out, particularly on the pump and treatment side of things. We’ve seen an increase of things like variable -speed-drive technology. We install quite a bit of that product now. People are moving out from the city and want to keep city pressure.”
Approaching his five-year anniversary as owner of the business, Carson is happy with its size and growth. The rural
nature of his service area combined with an increase in immigration of skilled professionals to the region has translated into steady work. “We’re able to live a good life doing service work, repairs and drilling about 50 wells a year. I make a living for my family and my father still comes in as well during the summer months to help.”
The new challenge for Carson is learning to balance long workdays with a young family. With two children under the age of three and a successful business, there is little time for rest. Perhaps Carson’s grandfather was in a similar position 68 years ago and no doubt would be pleased to know his great-grandchildren are nurtured by the company he founded.

INDUSTRY NEWS
I SLANDE r S INvITED To pArTICI pATE IN Cr EATI oN oF WATE r ACT

The government of Prince Edward Island is inviting all Islanders to participate in the creation of legislation to protect water quality and quantity now and into the future.
Prince Edward Island is the only Canadian province dependent entirely on ground water for drinking water. As a result, the government says a provincial Water Act will have to provide water security, offer guidance for government decisions involving water management and put legislation in place that will allow water challenges to be effectively addressed.
“The overall objective of a Prince Edward Island Water Act will quite simply be to ensure the protection of our water,” said Minister of Communities, Land and Environment Robert Mitchell. “Today, we are releasing a white paper and launching
our primary phase of consultations. The white paper outlines the components of an act that could be used to protect and conserve our water supply and is intended to serve as a resource for Islanders as we work together on legislation development.”
Consultations led by Prince Edward Island’s Environmental Advisory Council will be held across the province over the coming months – times, dates and locations will be advertised in advance. Jean-Paul Arsenault, who served as executive secretary to the Commission on Land and Local Governance, the Round Table on Resource Land Use and Stewardship, and the Standing Committee on Agriculture, Forestry and Environment, will serve as moderator of the consultations. Information gathered throughout the consultation process will aid in the drafting of the Water Act, which will be presented for public review and feedback in 2016.
“We look forward to hearing from Islanders on what is important to them in the development of this important piece of legislation,” said Richard Davies, chair of the Environmental Advisory Council. “Water management is imperative for all Islanders and that is why we encourage the public to participate in the consultation process.”
Islanders may offer input via in-person consultations, online submissions, e-mail, phone, mail and fax.
To learn more about the creation of Prince Edward Island’s Water Act, visit www.gov.pe.ca/wateract.


WATER QUALITY
Samplin G for bacteria
a review of methods suggests it’s a complex process
water well drillers familiar with the contaminated water outbreak situation in walkerton, o nt., will remember that issues with improper sampling for bacteria in the water supply were part of the problem.
A recent court case in southern Alberta deals with contamination of a water well on a residential acreage. Part of the dispute relates to sampling of the well, with the acreage owner stating that the water supply was improperly sampled for bacterial contamination by consultants and government agencies.
The acreage owner said insufficient sampling resulted in a non-detect result for fecal coliform bacteria, and that her own consultants collected samples that showed a considerable amount of fecal coliform bacteria in the well water.
A review of the methods for ground water sampling suggests this procedure is not necessarily straightforward. Typically, well drillers sample water from a well shortly after it is built. Sampling from an installed water well system is more complex, however, and water well drillers are advised to be cautious when sampling for bacteria in these installed systems.
One recent study conducted in New Jersey in wells where coliform bacteria are present found that they were detected in only about one-fifth of the wells sampled once, but the detection rate increased to over 40 per cent when the wells were sampled three times. The study estimated bacteria would be found in over 90 per cent of the wells if sampled 10 times.
Often sampling will be undertaken
using protocols such as wearing gloves to ensure bacteria from people’s hands are not introduced to the sample bottle, that the proper bottle and preservatives are used, and that the tap is run for a sufficient length of time prior to collecting a sample. These protocols are not enough. However, few formal protocols do exist, one of which is ASTM D3370 –10 (Standard Practices for Sampling Water from Closed Conduits). This standard emphasizes that the sampling represents only a point of sampling at the time of sampling.
by Ken Hu G o
Bacteria, unlike other parameters such as routinely dissolved salts, are not evenly distributed throughout the system. Besides the well itself, there are numerous components in a water system where bacteria may be found. Bacteria also may be found in the lines, pressure tank, cistern, hot water tank, and treatment and filtration units. Plumbing “dead ends” such as well sumps or unused water lines may be preferential spots for bacterial growth. The bacteria prefer to grow on iron pipes versus PVC (polyvinyl
one recent study found that the detection rate of coliform bacteria increased to over 40 per cent when wells were sampled three times; researchers estimated bacteria would be found in over 90 per cent of the wells if sampled 10 times.
chloride) or ABS (acrylonitrile butadiene styrene) and likely prefer copper pipes least of all.
Why not just sample at a drinking water tap in the kitchen, which is downgradient from all these units? Issues with this concept relate to how bacteria enter the water stream. The bacteria may not be continuous throughout the system but may exist in

•


colonies that slough off of solid surfaces at irregular intervals. A change in flow conditions often results in a spike in bacterial concentration. One study found that bacteria counts were higher when the tap was initially turned on than when the tap had been running for several minutes prior to sampling.
The acreage owner in the legal suit was stating that her well had not been used for several months prior to sampling. This may explain the nondetect result. Bacteria in the well would not show at the tap after running the tap for several minutes as the well water would not work itself to a tap over this short a time frame.
Is there a preferred way to sample for bacteria? Following the ASTM guideline, it would appear that several samples taken at several points with the water system in operation at various times would be appropriate. Samples could be collected relatively easily from the well, from the sampling valve at the pressure tank, from both the cold-water and hot-water taps, and from treatment or filtration units. Cisterns can be a source of contamination, so sampling directly from the cistern is a good idea.
Sampling from an end-point tap should be done as soon as the tap is turned on, after several minutes of flow and perhaps also when enough time has passed to allow water from the well to reach the tap, a process that could take over an hour.
Should a driller be involved in collecting samples for water quality? Certainly they could – but with an existing system the sampling needs to be conducted throughout the system and at various times.
When it comes to a well owner’s health, all efforts should be made to be thorough. Minimizing lab costs and personnel time is not a good enough reason to justify insufficient sampling.
Ken Hugo is a technical director and hydrogeologist with Groundwater information Technologies (G riT).

by Mi CHael Klee SP ie S
water-well remediation
chemical methods can combat common issues
ilike to compare maintaining a water well to owning a vehicle. m y first car was a h onda a ccord. a t 16 years old, the last thing i wanted to do was spend money on maintenance. i skipped changing the oil; i never considered that the many filters in the car needed to be replaced.
It did not take long before the car developed problems. Over the several years that I owned that car, it broke down several times. The breakdowns always resulted in a large bill to get the car up and running again.
Needless to say, I learned the lesson that a car needs regular maintenance to perform at its best. Regular maintenance also helps extend the life of your vehicle.
The same holds true for a well. Like a car, a well should have a scheduled well-maintenance plan. In the long run, it will extend the life of the well; keep it running efficiently and at full capacity; and save the well owner the costs associated with replacing pumps or drilling a new well.
To have a well drilled is an investment for
a homeowner. A water well should provide a reliable, consistent source of good-quality drinking water that should also last for a long period of time.
It’s important to properly maintain a water well. To do so, you must understand the attributes of the well. A lot of people do not think about the importance of their water supply until something happens and they lose access to water.
How often a well needs to be serviced is a function of its geology. The geology of the aquifer type will also dictate the quality of the water. A well drilled in an alluvial deposit will need more frequent maintenance than a well drilled in a limestone aquifer. Other aquifer types include sandstone, interbedded


The Flagship GEFCO 30K is still a Leader in the Industry. Mounted on a 6x4 truck, the 30K is perfect for shallow municipal or deep residential water wells. With 40,000 lbs. (18,140 kg) of top head hoist and 25,000 lbs. (11,340 kg) single -line winch combined with the hydraulic rod spinner makes tool handling fast and easy. For additional information on the 30K and other GEFCO products, visit our website: www.gefco.com or like us on Facebook for updates and product photos: GEFCO, Inc.


LEFT: Biofouling is caused when naturally occurring bacteria interact with the components of the well and form a slimy deposit often referred to as iron bacteria. r IGHT: The colour of the mineral scale can indicate the type of scale: red/brown suggests iron, black suggests manganese, green/blue suggests sulphates and white suggests calcium.
sandstone and shale, and consolidated sedimentary. The majority of wellproduction problems will fall under three conditions. These issues can be limited by both a properly constructed well and regular maintenance (including well rehabilitation).
Basic preventive maintenance costs are roughly 10 to 20 per cent of the cost for a full well rehabilitation. A full well rehabilitation is roughly 10 to 20 per cent of the cost of having a new well drilled. Like a car, the cost to fix a well that you have not maintained will increase rapidly the longer you put it off.
MINERAL SCALE
Mineral scale is a very common cause of reduced well production or complete failure. This mineral incrustation is caused by the precipitation of dissolved minerals on the well screen and pump from the ground water. The chemistry of the ground water has the biggest influence in determining how quickly this scale will build up. The chemistry of the ground water in turn is determined
by the geology of the aquifer. The regular use of water wells and the high velocity at which the ground water is pulled through the screens and into the pump accelerate the deposits of the incrustation. The colour of the mineral scale can give an indication of the type of scale:
• iron = red/brown
• manganese = black
• sulphates = green/blue
• calcium = white
Periodically testing the ground water for concentrations of these substances will allow you to come up with the frequency of maintenance required for the well.
BIOFOULING
Biofouling is caused by the accumulation of bacteria on the well screen and pump. This phenomenon is caused when naturally occurring bacteria interact with the components of the well and form a slimy deposit often referred to as iron bacteria. The problems associated with bacteria buildup are clogged screens
and a reduction of pump efficiency. The buildup of living and dead bacteria can accumulate quite rapidly and can cause the start of mineral incrustation. Symptoms of a well affected by biofouling include a quick decline in the output of a well due to clogged screens and biofilm on pumps. The problem can also lead to reduced water quality resulting in the water having a bad odour or even a greasy sheen. In the long term, excessive biofilm can also cause corrosion of the well.
PHYSICAL PLUGGING
As water is pumped from a well, the resulting turbulence in the aquifer may slowly lead to the deposition of fine particles in the water-bearing formation. This often results in a slow reduction in the capacity of the well over the long term. Typically, this is not much of a problem if the well is cleaned out (developed) properly when constructed. A well that has been developed sufficiently in the construction stage removes remnants of bentonite drilling fluid and fines deposited during the
drilling stage. Well corrosion resulting in pits and holes forming on the well screen or casing will also lead to the accumulation of sediment in the well.
Physical plugging is also a result of the use of the well beyond its design capacity.
In order to maintain your well and determine if one or more of these problems may need to be addressed, a homeowner requires some benchmark information. In the event that a homeowner switches contractors, the following information is needed as a reference to determine a reduction in the performance of the well:
• static water level (the elevation of the standing water in the well)
• specific capacity of the well as determined by a pump test (along with pump rate, pump level, pumping time)
• water-quality analysis
• depth of the well
Because all new wells in Canada must be registered, this information can be found if misplaced or not provided when purchasing an existing property with a well. A basic rule of thumb is that well rehabilitation is required if the specific capacity of the well is reduced by 25 per cent or more.
REHAB METHODS
heat or shockwaves. A brief description of a typical well-rehabilitation process starts with using a mechanical brush to loosen up and facilitate the removal of mineral scale and biofouling. This works the same way as a chimney brush. This is followed up by the introduction of a surfactant, which is surged through the well over a period of time to soften and loosen the incrustation by increasing surface tension. The surfactant will open up access to fissure and cracks within the buildup.
Once the surfactant has had sufficient time to work, it is purged from the well. The well or pump contractor will then dose the well with a chemical designed to dissolve, suspend and carry out the bacterial deposit that has built up in the well. This process may be quick or may take 24 hours or more, depending on the severity of the deposit. The chemical should be moved throughout the well at this time through the use of surging, jetting, displacement or recirculation. This allows for the penetration of the chemical and removal of the biofilm in the well and surrounding area. As this chemical is an acid, the pH is monitored to determine if the acid is degrading and more needs to be added.
Once the well water returns to neutral or is pumped out, another chemical is
added to tackle the mineral incrustation. As mineral scale is often very hard, it may take longer to break down and dissolve. Again, this acid must be surged through the well into the formation. A cable-tool rig is particularly useful to surge or jet a well through the wellrehabilitation process.
When it is determined that the mineral scale has been removed, the well is pumped clean of the chemical and it can then be chlorinated. At this point, the specific capacity of the well is tested and recorded. Well rehabilitation should always be performed by a licensed contractor.
A little education as well as a good working relationship between a well and pump contractor and a well owner will ensure that a water well runs efficiently and produces the best quality water based on the geology of the aquifer. A water well, like a vehicle, requires regular maintenance and TLC to keep it in good operating condition.
Michael Kleespies is the Canadian Territory Manager for C eTC o drilling Products, a manufacturer of highquality drilling fluids, bentonite grouts and sealants, and well rehabilitation chemicals. C eTC o serves the water well, environmental, geothermal and construction drilling markets.
A well is typically rehabilitated using a combination of mechanical cleaning and well-rehabilitation chemicals. Some companies use other techniques such as
Beauregard_7x3.25 3/21/06 7:45 AM Page 1


ASSOCIATIONS
o G wa conference
news and research from the June convention
whether it was a lively round of golf, a 45-minute hike to a university of Guelph research site or a relaxed casino night, members of the ontario Ground water association were game.
by Colleen Cro SS
The o GWa announced a new board of directors at its aGM. Front row, left to right: treasurer/secretary Chris Gerrits, Paul Conrad, president darren Juneau, first vice-president Bryan Watson, second vice-president Matthew Wilson and Sean Holmes. Back row, left to right: david Sawicki, dave nahrgang, Stephen Bleizeffer, past president dave Gunn, dave Moore, robert Martini and dwayne Graff. absent from the photo: Mary Jane Conboy
Members got together for the association’s yearly conference and annual general meeting at the Delta Guelph Hotel and Conference Centre in Guelph, Ont., June 5 and 6.
Nearly 100 hit the links for Friday’s golf tournament and nearly 150 attended the evening’s mixer, executive director Craig Stainton said.
During a Saturday session, Fleming College’s Gordon Bailey updated members on news about the past year’s Resources Drilling and Blasting program, which this year celebrates its 40-year anniversary. He announced several new courses, including a welding course on Nov. 28, 2015; a pumps course on March 1, 2016; and a pending course on disinfection.
The college has made Best Management Practices 1 available to purchase for $240 and
is hoping to offer BMP 2 as well in future.
On Saturday afternoon, president Darren Juneau gave attending members, who numbered about 50, a brief update on the progress of talks between OGWA and the Canadian Environmental Law Association (CELA). The law association had identified loopholes in the new Ontario Reg. 903 that could potentially lead to litigation. Juneau and executive director Craig Stainton met earlier this spring with CELA to discuss the regulation and potential issues that may arise from it. The associations are talking, Juneau said, but it’s expected to be at least a year-long process.
Following the conference sessions, about 40 hale and hearty members took a pleasant – if at times hot – stroll through the University of Guelph Arboretum to the university’s Bedrock


Absolute Precision Technology
The Levelogger Series of dataloggers are selfcontained water level recorders that use a durable, corrosion-resistant Hastelloy pressure sensor and powered by a lithium battery.
The Levelogger uses infra-red data transfer to communicate optically, eliminating direct electrical connection. Because of this unique feature, along with the Levelogger’s faraday cage design, Solinst Leveloggers benefit from protection against power surges and lightning strikes.




at the Bedrock aquifer Field Facility (BaFF), researcher Patrick Quinn describes research using the Straddle Packer system, wherein a hose is inserted into a test well, then filled with water to push it flush to the edge of the well and keep out contaminates. “you’re replacing the liner in the hole with the new liner...an ingenious invention,” Quinn said.
Aquifer Field Facility. Participants, including hydrogeologists, well drillers and equipment distributors, were impressed with the depth and breadth of research occurring at the facility, which consists of a workshop where equipment and core samples are housed, educational trailers and two boreholes. Dr. Beth Parker and her research team walked participants through seven stations detailing the extensive and promising work they are doing.
Parker is director of the Centre for Applied Groundwater Research, which is carrying out federally funded field research across Ontario, in other provinces and in the United States on, among other subjects, well contaminates. The field research site is a beehive of activity, with Parker and her team conducting research on source water protection in collaboration with Guelph and other municipalities; new methods for collecting ground water/surface water interaction at the nearby Barber Scout Camp; nonpoint source contamination by nitrate in Ontario; and contaminated sites.
Saturday evening, about 100 members and families attended the banquet to socialize with colleagues and hear guest speaker David Rudolph, professor in the University of Waterloo’s earth and environmental sciences department. Rudolph, who specializes in regional hydrogeology and ground water protection and management, highlighted some emerging challenges for ground water worldwide. Forty per cent of the Earth’s land area is used for agriculture, he said, and agriculture accounts for 70 per cent of global fresh water withdrawal. By 2050, food demand may increase by 70 per cent and agricultural water demands may increase by 50 per cent, putting a strain on supplies.
Rudolph highlighted a couple of local success stories he has been involved in, including de-icing mitigation in Waterloo region, whereby road salt was measured to try to estimate how much was getting into the ground water, with an overall goal of reducing salt application on local roads by 25 per cent. He and colleagues installed monitoring wells by drilling at the curb where salt usually gets trapped. The unsaturated,


LEFT: ron and Shawn Hopper of W.d. Hopper & Sons ltd. of Seaforth, ont., accept an award and congratulations for prospering after an impressive 100 years of operation. r IGHT: John Wilson and Bill Morrison catch up after the annual general meeting.
or vadose, zone just below the curb holds three to four years’ worth of road salt data, he said, adding that they achieved a reduction of about 22 per cent. “It’s proof we can manage problems without resorting to water treatment,” he said.
Retiring board member Rob MacKinnon was presented with the Tenacity Award for his faithful attendance despite numerous obstacles, presenter Craig Stainton joked.
OGWA office manager Anne Gammage was recognized for her years of assistance to the association and various research groups.
Ron and Shawn Hopper of W.D. Hopper & Sons Ltd. of Seaforth, Ont., accepted an award and congratulations for
prospering after an impressive 100 years of operation in the water well drilling industry.
Mark Livingston from Soil Test in Dundalk and London, one of some 40 members who trekked out to the BAFF site, said he thoroughly enjoyed the conference. “If you don’t come to the show, you don’t realize how much the association is doing that you, as a well driller, benefit from,” Livingston said.
Executive director Craig Stainton said the association is doing more and more outreach to related associations and ministries, such as the Ministry of Municipal Affairs and Housing, to “make sure we are on the same page.”

NEW P RODUCTS
C ONVENIENT PERISTALTIC PUMP

Solinst’s new reversible-flow peristaltic pump is designed for water or vapour sampling from shallow wells and surface water, and for rugged field use.
The metal case is robust, compact and lightweight, the company said in a press release. It has no vents, grates or openings, making it water resistant, easy to use in the field, and easy to maintain and repair. The pump connects to a 12V power source to operate.
One easy-access control allows high or low-flow sampling. The pump can be fitted with two sizes of silicone tubing. Standard 5/8 in. tubing can give flow rates to almost 3.5 L/min., while optional 3/8 in. tubing allows rates as low as 40 ml/min, suitable for lowflow sampling. Pump tubing connects to smaller diameter down-hole tubing with ease, for high sample integrity. The pump is effective to depths up to the suction lift limit, as much as 33 ft. at sea level and for sampling in Solinst drivepoint piezometers, the company said.
www.solinst.com
I N-S ITU RELEASES
A NDROID VERSIONS OF WATER-q UALITY APP
In-Situ’s smartphone technology for water quality monitoring is now available on Android operating systems.
The new VuSitu Mobile App expands the functionality of the iSitu Mobile App to Android users. The industry’s first smart-
phone application for environmental monitoring, iSitu, transformed the way environmental professionals collected water quality data by eliminating the need for bulky, expensive, handheld meters, said In-Situ in a press release.
In-Situ released the smarTROLL handheld instruments and the iSitu Mobile App in 2013. The system includes a compact probe with field-tested smart sensors and a weatherproof clip-on battery pack with Bluetooth wireless technology. The release of the handhelds and mobile app pairing allowed for instant access to multiple water-quality parameters.
VuSitu has the features and functionality of iSitu but with updated navigation and the new look and feel. Both versions of the mobile app simplify data collection and guide users through configuration, calibration, setup, and data management. Real-time results can be emailed from the field, logged to a mobile device, or exported on the spot. Site information can be consolidated on a mobile device, and data can be tagged with site photos and GPS coordinates. Both mobile applications are free to download, offering users a low cost and simple way to obtain and analyze data using the smarTROLL Handheld Instruments.
Designed for spot-checking and vertical profiling, the smarTROLL Multiparameter Handheld measures 14 water quality parameters, and the titanium smarTROLL RDO Handheld measures four parameters. Both instruments feature EPA-approved Rugged Dissolved Oxygen (RDO) technology for instantaneous DO determinations, and both interface with the iSitu and VuSitu Mobile Applications. Separate battery packs are
required for iOS and Android operating systems. www.in-situ.com
S ENSORE x UVT-LED MONITOR PORTABLE
open-channel configuration or directly in a pressurized pipe. Its small size makes it suitable for retrofit installations.

The UVT-LED, distributed exclusively by Sensorex, employs UV-C LED technology. The compact monitor, formerly known as the PearlSense T254, delivers fast, accurate transmittance readings in the field, water treatment facilities or industrial settings, the company said in a press release.
Transmittance measurement with the UVT-LED is designed for proper UV dosing and efficient operation. Its compact design uses mercury-free UV-C LED bulbs, and the unit works as either a handheld portable meter or an in-process instrument. The LED light source is ready for instant operation with zero warm-up time. It is capable of battery- and solar-powered operation, and is designed for long lamp life with little maintenance and low operating costs.
With a clear backlit LED display, the UVT-LED takes automatic measurements every 60 seconds. Integrated wiping prevents fouling and buildup in all water conditions, and a selfcalibration check helps ensure continual accuracy. The handheld model comes with battery power and convenient carrying case for use in the field and lab. The continuous model for in-process use runs on 24 VDC power, and can be used in an
UV transmittance values are used to track changes in water quality and detect the presence of organic compounds and other issues.
www.sensorex.com
TR-71NW TWO-CHANNEL TEMPERATURE DATA LOGGER FROM T & D
The TR-71nw supports automated, error-free data collection, remote monitoring and alerting with a simple Ethernet LAN connection.
Its features include twochannel temperature monitoring, ethernet connection to a local area network (LAN), automatic uploads to TandD’s free online storage service, web-based alert emails, use of

a free ThermoWeb App for both iOS and Android, and free software through a USB connection.
The system supports web-based and local data archiving. It operates through the ethernet or on two AA batteries for up to one-and-ahalf years.
The TR-71nw measurement range is -40 to 110 C (supplied sensor) or -60 to 155 C (optional sensor: fluoropolymer-coated type) with resolution of 0.1 C.
www.tandd.com
1494 Bell Mill Road, P.O. Box 456, Tillsonburg, ON, Canada, N4G 4J1 P.O. Box 2663, Buffalo, NY, USA, 14240-2663
Phone: 519.688.0500 Toll Free: 800.387.9355 Fax: 519.688.0563 Email: wells@wellmaster.ca Online: www.wellmaster.ca

Protector Vaults
Above Ground Locking Protectors
Submersible Pumps

WATERING NORTH AMERICA SINCE 1929.
The Woodford Y34 IOWA hydrant™ has been a North American icon for over eight decades. Every day, from the suburbs to the most remote farms, from the searing heat of a Texas summer to brutal Alberta winters, Y34s are delivering precious water reliably and efficiently. They won’t freeze. Repairs—not that they’re often needed—can be made without removing the hydrant. Parts are always available. And, this North American icon is made in America. Just like it has been since 1929.


